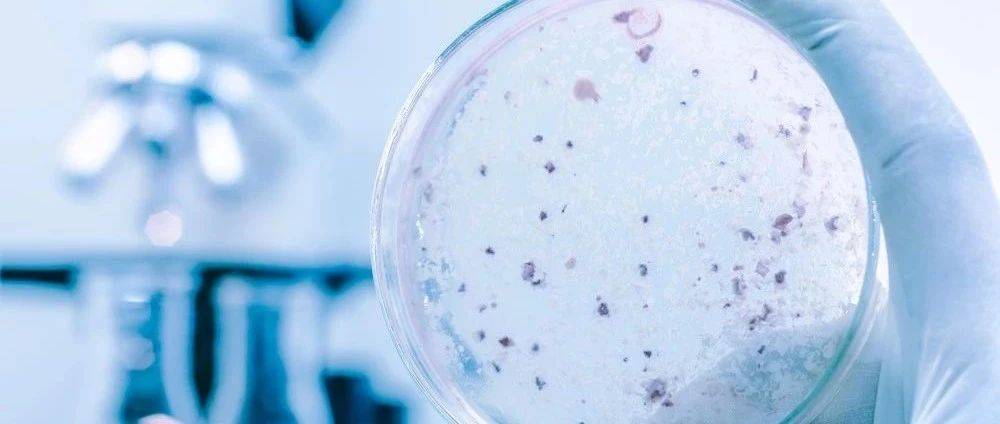

来源:生物探索
肠道良性肿瘤的癌变速度加快,与两个抑癌基因——Nedd4和Nedd4l的突变有关,该研究工作由弗朗西斯·克里克研究所的科学家们完成,并发表在《EMBO Journal》期刊上。

DOI: 10.15252/embj.2019102771
研究者利用RNAScop原位杂交(in situ hybridisation,ISH),发现Nedd4主要表达在隐窝干细胞区,而Nedd4l均匀分布于隐绒毛轴,两个基因表达的酶蛋白——神经元前体细胞发育下调蛋白4(Neuronal precursor cell developmentally downregulated protein 4, NEDD4)和同源蛋白NEDD4L可以抑制Wnt通路,后者在细胞生长和测定中有重要作用。

Nedd4和Nedd4l的缺失可促进肠隐窝增殖
之后,研究者移除小鼠和肠道器官中的Nedd4和Nedd4l基因,发现这两种基因的长时间缺失,会促进肠干细胞 (The intestinal stem cell, ISC)和隐窝(crypt)的增殖,此外,研究者移除了良性肿瘤中的Nedd4和Nedd4l基因,发现肿瘤会产生更多干细胞,且癌变速率明显加快。

NEDD4/ NEDD4L介导的Wnt通路调控机制
机制上,NEDD4和NEDD4L均通过靶向LGR5受体和DVL2,进行蛋白酶体和溶酶体降解,从而负调控Wnt/β-catenin信号。第一作者Laura Novellasdemunt指出,通过了解这两种基因的缺失对肿瘤的影响,以及它在癌症进化中的重要性,有助于进一步探究可减缓肿瘤发展的新疗法,如阻断Wnt通路。
End
参考资料:
[1] Two genes slow down the development of intestinal tumors
[2] NEDD4 and NEDD4L regulate Wnt signalling and intestinal stem cell priming by degrading LGR5 receptor
来源:biodiscover 生物探索
原文链接:https://mp.weixin.qq.com/s?__biz=MzU2MTQ2MDE0Ng==&mid=2247509733&idx=2&sn=1034c18294355c65fbe1db9684cb601d&chksm=fc7a8038cb0d092e04aa6194bf91cb43ee13a0a09c7ca8d2ba384291bf1f96243438737b0af6#rd
版权声明:除非特别注明,本站所载内容来源于互联网、微信公众号等公开渠道,不代表本站观点,仅供参考、交流、公益传播之目的。转载的稿件版权归原作者或机构所有,如有侵权,请联系删除。
电话:(010)86409582
邮箱:kejie@scimall.org.cn